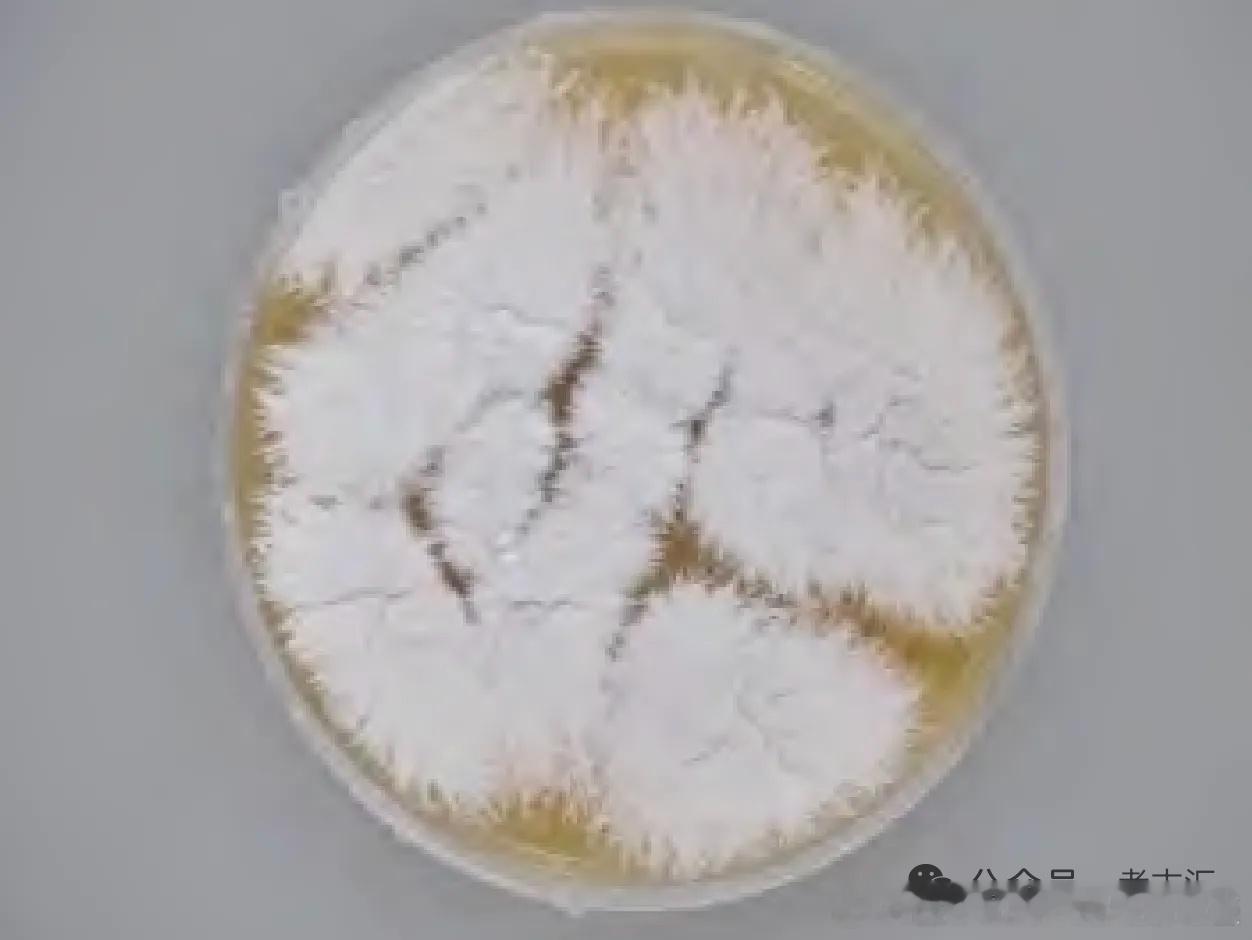

北朝考古 考古出土脆裂毛织品的揭取与保存工艺研究——以山西大同北魏金茂府M29毛织残片的修复为例网页链接
引 言考古出土的脆弱纺织品,依据其保存状态和埋藏环境,大体可分为北方干燥地区与南方潮湿(保水)地区两类。二者因温湿度、土壤成分、微生物活动差异,呈现出截然不同的脆弱性特征,对应着差异化的提取、加固与长期保存策略。在黄土高原环境下出土的纺织品,因长期处于季节性埋藏环境,温湿度差异大,不仅低湿度、微生物干扰多,还容易出现碎裂、脆化、纤维粘连等病害特征,给原位提取和妥善保存增添难度。因此,本次以提取和保存北魏金茂府M29出土毛织样品为例,基于样品的分析检测结果,再比较国内外脆弱纺织品揭取和保护的相关工艺,运用加固插板法和夹持封存法,完成这件脆弱毛织样品的保护修复工作,进而为北魏墓葬的葬制葬俗、毛织工艺等研究提供相关的实物资料,最终实现“延长文物寿命、保留历史信息”的核心目标。
刊于《文物季刊》2025年第4期。